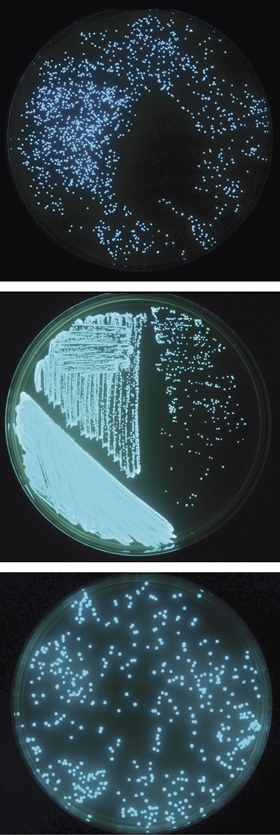
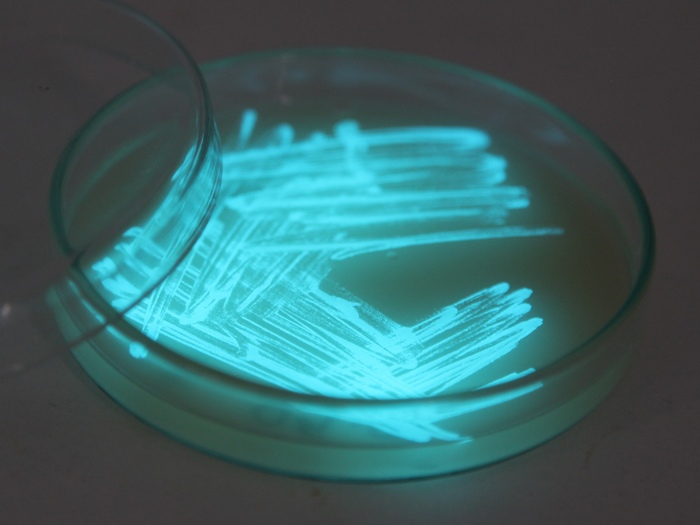

Physarum polycephalum. Фото: Mushroom Observer
Первую и вторую части можете найти в моём профиле, ВК и telegram.
Telegram: https://t.me/biology_arx
ВКонтакте: https://vk.com/world_of_biology
Twitter: https://twitter.com/arx_atrata?s=09
Перейдём к заключительной части.
Род Арцирия—Агсугiа Wiggers
Спорангии цилиндрические, овальные или округлые, на цилиндрических, довольно коротких ножках или без них, 1-2 мм высотой. Преобладают желтая, красная, серая окраски. Перидий тонкий, разрывающийся при созревании спороношения в верхней четверти кругообразными трещинами; после этого верхняя его часть отпадает, а нижняя остается в виде чашечки, к основанию и бокам которой прочно прикреплен сетчатый эластичный капиллиций. После вскрытия спорангия капиллиций растягивается, вдвое и более превышая первоначальный размер спорангия. Оболочка капиллиция с поперечными кольцеобразными утолщениями или полукольцами, бородавками, шипиками и т.п. Капиллиции, как и споры, у большинства видов окрашены в цвет спорангия, у некоторых — в массе почти бесцветны. Более 20 видов.
Арцирия оголенная — А. Denudata (L.) Wеttst. Плазмодий белый, терракотовый или карминно-красный. Спорангии скученные, овальные или короткоцилиндрические, конусовидно суживающиеся кверху, сидят на темных, продольно-полосатых ножках. Общая высота спороношения (1,5) 2-6(7) мм, ширина 0,4-1,2 мм. При созревании перидий разрушается и остается только в виде чашечки в основании спорангия. Чашечка несет на поверхности радиально расположенные складки. От нее отходит сетчатый капиллиций, прикрепляющийся ко всей ее внутренней поверхности. Длина капиллиция в 1,5-2 раза больше длины невскрывшегося спорангия. Окраска капиллиция и массы спор такая же, как и окраска перидия. Встречается повсеместно с июля по октябрь на гнилых пнях и деревьях, на коре, на засохших ветвях, иногда в оранжереях, вегетационных домиках и других подобных постройках.
Арцирия поникшая—А. nutans Grеv.
Плазмодий беловатый, водянистый. Буровато-желтые спорангии скученные, сидячие или на ножках и вместе с ножкой достигают 1,5-2 мм высотой. Капиллиций в виде сети буровато-желтого или охряного цвета, вытягивающийся вдвое после отпадения перидия и свисающий верхним концом вниз. Капиллиций не прикрепляется к стенке чашечки, остающейся после разрушения перидия, и поэтому легко сдувается ветром вместе со спорами. Споры в массе охряно-желтые или буроватые. Встречается реже, чем предыдущий вид, на гнилых деревьях, пнях, ветвях с июля по октябрь.
Род Гемитрихия— Hemitrichia Rost. Спорангии булавовидные, продолговатые или округлые, сидячие или на ножках, реже в виде продолговатых, извилистых или сетчатых плазмодиокарпиев. Окраска от желтой или красно-бурой до черно-оливковой. Перидий перепончатый или полухрящеватый, обычно сохраняющийся в виде чашечки в основании спорангия. Капиллиций состоит из сети цилиндрических волокон более или менее многочисленными свободными концами и со спиральными гладкими или щетинистыми утолщениями (в количестве двух спиралей и более). Окраска капиллиция и массы спор примерно того же цвета, что и окраска перидия. Род занимает промежуточное положение между родами Trichia и Аrcyria (спирально идущие утолщения на капиллиции— как у видов рода Trichia, а разветвления в виде сети — как у видов рода Аrcyria). Около 10 видов.
Гемитрихия осиногнездная — Н. vesparium Мacbr.
Плазмодий пурпурно-красного цвета. Спорангии темно-красные, красно-бурые или черна-оливковые, блестящие, овальные, грушевидные или булавовидные, тесно скученные, сидячие или на ножках, часто слившихся в пучки по 6-12. Общая длина спороношения — 1,5-2,5 мм, ширина — 0,5-0,7 мм. Иногда развиваются плазмодиокарпии. Капиллиций в виде сети разветвленных оранжевых или темновато-красных цилиндрических нитей с много численными свободными заостренными концами. На нитях капиллиция 3-5 спиральных, как у рода Trichia, утолщений. Споры в массе красновато-бурые. Очень распространенный вид, встречающийся на гнилых пнях, засохших деревьях с июля по октябрь.
Во второй части мы рассматривали примеры «коллективного разума» и способности слизевиков принимать решения, из всего этого, можно сделать вывод, что слизевики вполне способны и к обучению. За решение этой задачи взялись японские учёные (ссылка на статью в Physical Review Letters дана в конце). Объясню кратко смысл их эксперимента. В качестве испытуемого, они взяли Physarum polycephalum (и да, как вы можете наблюдать, с ним работают практически во всех исследованиях), далее его поместили в инкубатор, где поддерживалась комфортная влажность и температура для его развития и миграции (26°С при 90% влажности). Затем, на 10 минут благоприятную среду решили нарушить, снизив температуру до 23°С и влажность до 60%. Смену условий провели несколько раз, с интервалом 50-60 минут. За это время они наблюдали интересную реакцию слизевика, который при первом снижении, замедлил своё продвижение, но уже при повторах, он снижал свою скорость заранее, в ожидании негативного воздействия.
Если воздействия не происходило, то слизевик забывал об этом. Иногда, даже если ничего не происходило, он всё равно замедлялся. Но спустя многие часы покоя, стоило лишь один раз понизить показатели, то механизм срабатывал – слизевик возобновлял свои остановки каждый час.
Вывод: Physarum polycephalum обладает памятью, у него, как и у многих живых организмов имеются собственные биохимические «часы», которые позволяют соблюдать ритм в окружающей их среде.
_____________________________
ПОРЯДОК ФИЗАРОВЫЕ—РНYSARАLЕS
Самый большой по числу видов. Для видов этого порядка характерны большие скопления извести, главным образом на поверхности перидия, на капиллиции, на ножке спороношения, на гипоталлусе (обнаруживаются визуально или при действии соляной кислоты). Плазмодий сильно гранулированный, у одних родов бесцветный, у других — окрашенный в яркие цвета. Спороношения в виде отдельных спорангиев, сидячих либо на ножках, или эталии, или плазмодиокарпии. Капиллиций чаще из ветвящихся нитей, образующих узловые расширения, на которых отлагается известь. Споры в массе тёмно-пурпурные, фиолетово-коричневые, темно-коричневые до черных. Два семейства, 15 родов, около 200 видов.
СЕМЕЙСТВО ФИЗАРОВЫЕ - РНYSARAСЕАЕ
Известь в виде аморфных гранул.
Род Леокарпус—Leocarpus Link
Леокарпус ломкий — L. fragilis (Diсks.) R о s t.
Плазмодий желто-оранжевый и покрывает субстрат как бы пенистой массой. Спорангии тесно скученные или расположенные паучками, 2-4 мм высотой, грушевидные или короткоцилиндрические, слегка суживающиеся книзу, реже почти шаровидные, сидячие или чаще висячие на мягкой, не очень длинной, иногда беловатой ножке, образующейся как продолжение кожистого гипоталлуса такого же цвета. Окраска спорангиев буровато-желтая пли каштаново-коричневая. Перидий хрупкий, блестящий, как бы лакированный снаружи, неправильно растрескивающийся при созревании. Капиллиций в виде сети из бесцветных разветвленных, уплощенных тонких нитей, соединяющих жесткие белые расширения или вздутия (узлы), на которых располагаются известковые гранулы. Споры в массе черные. Широко распространенный вид, повсеместно встречающийся с июля по сентябрь на гнилых деревьях, засохших листьях и мхах; при этом на мхах часто преобладают спорангии светло-охряной окраски, а на других субстратах — каштаново-коричневой.
Род Фулиго—Fuligo Haller.
Плазмодий пенистый, б. или м. объемистый. Спороношение в виде крупного эталия, плотно сидящего на кожистом гипоталлусе. Перидий хрупкий, толстый, содержащий известь. капиллиций состоит из очень тонких бесцветных анастомозирующих нитей, соединенных расширенными вздутиями (узлами), на которых расположены бесцветные или желтоватые гранулы извести. Споры фиолетовые до черных.
Фулиго гнилостный — F. septica (L.) Wiggеrs
Плазмодий ярко-желтый, реже белый или кремовый, достигающий иногда нескольких десятков сантиметров. Подушковидные эталии сильно варьируются в размерах, форме и окраске: 0,2-20 см длиной, 1-5 см толщиной, белые, охряные, зеленоватые, розоватые, тускло-красные, почти коричневые. Довольно толстый, но хрупкий перидий, содержащий известь, легко разрушается и отслаивается кусками, обнажая почти черную массу спор. Чрезвычайно распространен с июля по октябрь на гнилых пнях, на земле, на коре ветвей, засохших листьях, в оранжереях и т. п. В дождливые дни может так быстро и мощно разрастаться, что покрывает несколько квадратных метров газона.
Fuligo septica. Фото: NorbertNagel
Род Физарум—Physarum Регs.
Плазмодий белый, сероватый, желтый или оранжевый. Спорангии б. или м. округлые, сидячие или на ножках, иногда в виде продолговатых изогнутых плазмодиокарпиев. Перидий хрупкий, с известью (реже без нее), неправильно растрескивающийся при созревании. Капиллиций в виде сети тонких разветвленных нитей, прикрепленных к основанию спорангия или к различным участкам перидия, с многочисленными расширениями и вздутиями, содержащими бесцветные или окрашенные гранулы извести. Споры в массе фиолетовые до черных. Род с широкой амплитудой изменчивости и самый большой по числу видов (более 80).
Физарум пепельный — Р. cinereum (Ваtsсh.) Реrs.
Плазмодий бесцветный или белый, перед образованием спороношения желтеющий. Спорангии помногу вместе, 0,3-0,5 мм шириной, сидячие, округлые, продолговатые или реже сливающиеся в короткие извилистые плазмодиокарпии. Перидий тонкий, шероховатый, белый или пепельно-серый, покрытый известью сплошь или местами, иногда почти без извести и радужно переливающийся. При созревании спорангия перидий разрывается неправильно в виде продольной щели, и обнажаются обильно развитый и покрытый известью капиллиций и пурпурно-коричневая или фиолетовая (до черной) масса спор.
Очень обычный вид, широко распространенный с июля по октябрь, часто образующий спороношения на живых растениях, на отмерших листьях, на подстилке. Описаны случаи массового появления этого слизевика на газонах и гибели при этом травянистых растений и проростков древесных пород.
Физарум многоглавый — Р. polycephalum Sсhwеin. Плазмодий иногда вначале бесцветный, затем ярко-желтый или зеленовато-желтый. Спорангии на длинных извилистых, чисти поникающих ножках, вырастающих от широкого кожистого гипоталлуса, плотно прижатые друг к другу по 3-10, желтые, желтовато-серые, серые, иногда белые, неправильные, сливающиеся и тогда похожие на грибы-сморчки, только очень маленькие (общая высота 1,5-2 мм). Перидий тонкий, хрупкий, покрытый быстро исчезающими желтыми или беловатыми кучками известковых гранул. Капиллиций плотный, в виде рыхлой сети нежных тяжей с желтыми или белыми узлами неправильной формы. Споры в массе фиолетово-коричневые до черных. На мертвой древесине; плазмодий иногда встречается на грибах с мясистыми плодовыми телами, покрывая пластинки и трубочки шляпок и поглощая споры и сочные части шляпок. Плазмодий этого вида легко культивировать в условиях лаборатории, поэтому он стал объектом интенсивного изучения.
Итак, память есть, реакция есть и самое главное есть разум, хоть и коллективный, но есть! Не хватает только творческих способностей. Как оказалось, и с этим всё хорошо.
В 2012 году группа английских исследователей установили электроды в чашку Петри, где на тот момент уже был выращен Р. Polycephalum. Каждому из электродов были присвоены частоты, после чего все электрические сигналы были преобразованы в звук. Что из этого вышло можете посмотреть на видео.
Профессор Плимутского университета Эдуардо Миранда считает, что Р. Polycephalum возможно использовать в создании нового музыкального звучания.
Если пропустить через слизевика слабый электрический ток, то он ведёт себя словно электронный элемент, называемый мемристром.
_____________
Мемристор – это резистор, сопротивление которого изменяется под воздействием, протекающего через него тока. Появление этого элемента электроники выведено математически и описано в 1971 году инженером Калифорнийского университета Леоном Чуа. Собственно, Чуа и дал ему название мемристор и теоретически он должен был стать 4 элементом электроники, совместно с резистором, конденсатором и индуктором.
Создан элемент был только в 2008 году.
_____________
Используя способности слизевика Э. Миранда сыграл небольшой совместный концерт. Задавая общий музыкальный ритм, в игру вступал Р. Polycephalum. Можете посмотреть видео концерта, любители альтернативного звучания, возможно оценят подобное.
Род Бадамия—Badhamia Berk.
Плазмодий белый или желтый. Спорангии яйцевидные или шаровидные, сидячие либо на б. или м. длинной ножке, обычно тесно скученные, реже одиночные, иногда сливающиеся в плазмодиокарпии. Перидий тонкий, с многочисленными гранулами по всей поверхности. Капиллиций из грубых расширенных плоских тяжей с известковыми гранулами по всей поверхности; тяжи образуют сеть, прикрепленную к стенкам перидия. Более 20 видов.
Бадамия пузырчатая — В. utricularis Веrk.
Плазмодий хромово-желтый, распростертый. Спорангии 0,5—. 1 мм шир., серые или с радужными отливами (иризирующие), удлиненно-яйцевидные, реже шаровидные или сливающиеся вместе и лопастные, сидячие или повисающие гроздьями на светло-желтых разветвленных перепончатых ножках, отходящих от гипоталлуса. На перидии мелкие гранулы извести в небольшом количестве, как и на капиллиции. Капиллиций сетчатый, из плоских широких тяжей, которые прикрепляются в разных местах к перидию. Споры буроватые или темно-фиолетовые, в плохо распадающихся кучках. Широко распространенный вид, часто встречающийся с мая по сентябрь на ветвях и стволах засохших деревьев и особенно на гниющих плодовых телах трутовиков и шляпочных грибов (Stereum hirsutum, Coriolus versicolor, Daedalea quercina, шампиньонов и др.).
Бадамия обманчивая - В. decipiens Веrk. Плазмодий ярко-желтый, распростертый. Спорангии в кучках, сидячие, уплощенные, иногда извилистые или в виде плазмодиокарпиев лимонного либо оранжевого цвета, с шероховатым, реже гладким перидием, покрытым желтыми гранулами извести. При созревании спорангии раскрываются сверху довольно широким отверстием с рваными краями. Капиллиций желтоватый, в виде сети широких, плоских тяжей. Споры буровато-фиолетовые до черных. Встречается реже, чем предыдущий вид, на сухих листьях, ветвях, гнилых пнях, сухих мхах с июля по сентябрь.
СЕМЕЙСТВО ДИДИМИЕВЫЕ — DIDYMIACEAE Известь в виде кристаллических образований (звездчатой формы или в виде угловатых пластинок), обычно на перидии. 6 родов.
Род Дидимиум—Didymium Schrad.
Плазмодий большей частью белый или серый, реже желтоватый. Полушаровидные, приплюснутые сверху спорангии сидячие или на ножке, реже распростертые и неправильно извитые плазмодиокарпии. Перидий бесцветный или крапчатый, тонкий, и кожистый, густо покрытый кристаллами извести, равномерно разбросанными по поверхности или собранными в плотные корочки. У большинства видов внутри спорангия имеется шаровидная колонка, иногда редуцированная до утолщенного известкового основания на дне спорангия. Капиллиций в виде ветвящихся анастомозирующих нитей, фиолетовых или бесцветных, без извести, часто с темными узловыми утолщениями. Споры в массе черные. Более 30 видов.
Дидимиум черноногий D. nigripes (Link) F r.
Плазмодий серый или почти бесцветный. Спорангии обычно группами, 0,5-0,7 мм в диаметре, снизу слегка расширенные, вогнутые, сидят на нежных темно-коричневых или черноватых (но нередко желто-бурых или оранжевых), продольно-полосатых ложках, расширенных в основании в виде гипоталлуса. Общая высота спороношения 1,5-2 мм. Перидий дымчатый, шероховатый, покрытый белыми известковыми кристаллами. Внутри спорангия имеется подушковидная приплюснутая колонка бурого, красноватого, чаще белого цвета, несущая известь. Капиллиций в виде нежных извилистых слаборазветвленных нитей, бесцветных или буровато-фиолетовых, с незначительными более темными местными утолщениями. Споры в массе темные. Встречается часто и повсеместно, главным образом в августе - сентябре, на отмерших ветках и листьях, на хвоинках и шишках, стеблях травянистых растений, на мхе, реже на древесине.
Род Дидерма—Diderma Реrs.
Плазмодий беловатый или желтоватый (у многих видов неизвестен). Спорангии округлые, б. ч. сидячие, иногда на коротких ножках, реже плазмодиокарпии. Перидий, как правило, двухслойный. Внешний слой хрящеватый, с многочисленными известковыми гранулами или из сплошной известковой, очень хрупкой и ломкой скорлупки. Внутренний слой тонкий, перепончатый, прозрачный, без извести. При созревании оба слоя перидия наверху разрываются звездообразно или неправильно, обнажая в основании спорангия полушаровидную или шаровидную колонку с отложениями извести. Капиллиций в виде густой сети разветвленных тонких, кое-где с утолщениями нитей фиолетового цвета или бесцветных, не содержащих извести. Более 30 видов.
Дидерма лучистая - D. radiatum (L.) Моrgаn. Плазмодий светло-желтый. Спорангии сероватые, красновато-бурые или бурые, шаровидные или вогнутые, около 1 мм в диаметре, сидящие на толстой, расширенной к низу короткой, но заметной ножке (0,2-0,5 мм) желто-бурого цвета. Толстый перидий раскалывается неправильно или продольной трещиной, образуя звездочку с закрученными и отогнутыми 4-8 лопастями, причем внутренний светлый слой перидия не отделяется от наружного. Колонка крупная (0,5 мм в диаметре), полушаровидная или круглая, в начале покрыта массой плотных лежащих темных, коричневато-фиолетовых спор. Когда споры рассеиваются, она обнажается как беловатая, бугорчатая от извести пуговка. Капиллиций в виде тонких, слабо вильчато-разветвленных и расположенных веерообразно фиолетовых или почти бесцветных нитей. Встречается летом на засохших листьях, мхах, кусках гнилого дерева, отмерших ветвях.
Вернёмся к теме электроники. В 2013 году было изучена мемристивная способность слизевика Р. Polycephalum. Естественно, что подобная область исследований открывает в будущем множество возможностей, в том числе для создания нейронных сетей.
В 2014 году учёные Германии и Великобритании создали на основе слизевика биокомпьютер, который способен выполнять простейшие логические задачи, ссылку на исследование я оставлю ниже.
Клаус-Питер Заунер из университета Саутгемптона (Великобритания) совместно с группой учёных университета Кобе (Япония) решила использовать все возможности Р. Polycephalum для управления шестнадцатеричным шагающим роботом. Они вырастили Р. Polycephalum в виде шестиконечной звезды на вершине цепи, а затем, посредством компьютера подключили его к шестипалому роботу. Датчики, расположенные в верхней части робота, использовались для управления светом (как помните слизевики светофобны), именно на основе воздействия света на слизевика и построено управление ногами робота. В попытках уйти от воздействия света, движение слизевика было обнаружено схемой, сигнал обрабатывался и одна из ног робота поднималась.
«Попытки сделать более сложные логические схемы на основе P. Polycephalum пока проваливались, но, возможно, именно слизевики однажды помогут людям сделать биосовместимую электронику, способную разговаривать на языке живых клеток. Кстати, такие исследования ведутся и в России — в группе Виктора Ерохина в Курчатовском институте: там уже создали небольшую искусственную нейронную сеть из мемристоров на основе электропроводящего полимера, а теперь хотят сделать полимерный транзистор, работа которого будет управляться электрической активностью слизевика» - цитата статьи информационного агенства ТАСС от 06.06.2016.
Все ссылки на исследования приложены ниже.
_________________________________
ПОРЯДОК СТЕМОНИТОВЫЕ Stemonitales
Плазмодий очень нежный, прозрачный. Спорангии или эталии. Плёнчатый, быстро исчезающий перидий и капиллиций не содержат извести (иногда она присутствует в гипоталлусе и в основании спорангия или реже в ножке и колонке). У большинства видов имеется колонка в виде продолжения ножки. Капиллиций нитчатый, часто в виде сети, обычно темный. Споры в массе красновато-коричневые, темно-фиолетовые или черные. Одно семейство.
СЕМЕЙСТВО СТЕМОНИТОВЫЕ - STEMONITACEAE
Содержит 15 родов и несколько десятков видов.
Род Стемонитис—Stemonitis Gled. Плазмодий белый (вначале прозрачный) или желтый. Спорангии 2-20 мм выс., цилиндрические, тесно скученные на блестящем, тонком перепончатом гипоталлусе, всегда на длинной тонкой темной ножке, продолжающейся в постепенно утончающуюся колонку, проходящую почти по всей длине спорангия. Перидий быстро исчезает, и обнажается капиллиций, состоящий из темных (одноцветных с колонкой и ножкой) веточек, отходящих от всей поверхности колонки и образующих вдоль всего исчезающего перидия нежную, б. или м. густую сеточку, вначале покрытую массой коричневых или почти черных спор. Когда споры рассеиваются, спороношение имеет вид очень изящных крошечных перышек. Более 15 видов.
Стемонитис бурый — S. fusca Rоtt.
Плазмодий белый. Спорангии 6-20 мм высотой, от светло- до тёмно-красно-коричневых. Ножка черная, блестящая, довольно длинная, составляющая иногда половину всей длины спороношения. Колонка темно-коричневая или черноватая, почти достигающая верхушки спорангия. Сеть капиллиция в периферической части с темными мелкими угловатыми петлями. Споры в массе тёмно-коричневые или буровато-фиолетовые. Очень обычный и широко распространенный вид, встречающийся главным образом летом и осенью (с июля по октябрь, а в оранжереях — даже с февраля) на гниющем дереве, отмерших ветвях, засохших листьях и других субстратах.
Род Лампродерма—Lamproderma Rost.
Плазмодий чаще белый, водянистый, реже желтоватый. Спорангии шаровидные, яйцевидные, эллиптические или цилиндрические, на б. или м. длинной черной голой ножке, редко сидячие, на плазмодиокарпии. Перидий плотный, кожистый, долго сохраняющийся, блестящий, с радужными переливами. При созревании спороношения перидий отделяется кусками, и только нижняя, утолщённая часть его остается в виде воротничка или чашечки в основании колонки. Черная цилиндрическая или булавовидная колонка представляет собой продолжение ножки внутри спорангии доходит чаще до половины или до 2/З высоты всего спорангия. Капиллиций в виде густой сети большей частью окрашенных нитей, которые радиально отходят от вершины колонки, утончаются и становятся светлее к периферии. Более 15 видов.
Лампродерма тонкосетчатая — L. Аrcyrionema Rost.
Плазмодий белый или водянистый, прозрачный. Серебристо-серые или радужно-бронзовые шаровидные спорангии (0,25)0,4 - 0,6 (0,75) мм в диаметре, сидят на тонких жестких, почти черных ножках, составляющих 2/3 —3/4 длины всего спороношения (общая высота спороношения 1-2,5 мм). После отрыва верхней части перидия основание его сохраняется в виде воротничка. Цилиндрическая тонкая темная колонка, достигающая 1/3 или половины высоты спорангия, разделяется на этом уровне на несколько толстых ветвей, которые в свою очередь многократно делятся, образуя конечные тоненькие веточки, согнутые и анастомозирующие друг с другом. Споры в массе черные. Встречается повсеместно, но не часто летом, особенно в августе, на отмерших листьях и древесине.
В конце, хочу ответить на вопрос одного из читателей Пикабу под первой статьёй о слизевиках.
Ответ:
Вырастить можно и в домашних условиях, но очень сложно. Для этого вам всё же понадобится оригинальный подопытный образец, который вы можете обнаружить в лесу. После чего образец нужно перенести в какую-либо ёмкость, а лучше в чашку Петри Ø = 90 мм. Таких образцов вам нужно достаточно много, несколько десятков, чтобы увеличить процент выживания образцов. Но перед всем этим, вам следует позаботиться о создании комфортной среды (температуры и влажности). Температура должна быть 25-26 градусов и влажности 90% в тёмном помещении. Как только комфортная среда налажена, образцы взяты и помещены в чашку Петри, нужно создать питательную среду. В качестве питательной среды можно использовать овсяные хлопья и агар 1-1.5%, и то и другое вы можете заказать в интернете. Этот субстрат необходимо выложить в чашку Петри, H = 2 мм (высота выкладываемого субстрата), Ø = 18 мм, можно выложить с двух сторон чашки. Скорость роста определяется создаваемыми условиями. Ссылку на пример эксперимента также прилагаю ниже. Надеюсь, что у вас всё получится. Удачи.
Спасибо за внимание.
Ссылки и полезные материалы:
1. Жизнь растений. В 6-ти т. Гл.ред.чл.-кор. Ж71 АН СССР, проф. Ал.А.Федоров. Т.2. Грибы. Под. ред. проф. М.В.Горленко. М., «Просвещение», 1976. 479 с. с ил.; 32 л. ил.
2. Грибы СССР/М.В.Горленко, М.А.Бондарцева, Г82 Л.В.Гарибова и др.; Отв.ред. М.В.Горленко.-М.: Мысль, 1980.-303 с., ил., 40 л. пл.-(Справочники-определители географа и путешественника).
3. Информация о профессоре Э.Морандо
https://www.plymouth.ac.uk/staff/eduardo-miranda
4. О мемристорах
https://www.newscientist.com/article/mg20327151-600-memristo...
5. Биосенсор
https://www.newscientist.com/article/dn11875-bio-sensor-puts...
6. Исследование о логической задаче
https://www.sciencedirect.com/science/article/pii/S136970211...
7. Исследование В.Ерохина
https://www.tandfonline.com/doi/full/10.1080/03081079.2014.9...
8. В.Ерохин на research gate
https://www.researchgate.net/profile/Victor_Erokhin
9. Музыкальные возможности слизевиков
https://www.newscientist.com/article/2142614-the-slime-mould...
10. Шестипалый робот и слизевик
https://www.newscientist.com/article/dn8718-robot-moved-by-a...
11. Память слизевика
https://www.pnas.org/content/109/43/17490.abstract
12. Исследование на возможность обучения
https://www.pnas.org/content/109/43/17490.abstract
13. Упоминания в прессе
https://lenta.ru/articles/2012/03/17/slime/
https://www.nytimes.com/2011/10/04/science/04slime.html?_r=1...
https://lenta.ru/news/2009/08/27/mould/
https://lenta.ru/news/2008/01/24/slime/
https://lenta.ru/news/2006/02/14/mold/
https://nauka.tass.ru/nauka/6820695
https://nauka.tass.ru/nauka/6817508
https://www.nature.com/articles/ncomms10938
https://hi-news.ru/research-development/video-dnya-uchyonye-...
https://medialeaks.ru/2911ttp-slizevik/
https://tass.ru/sci/6822035
https://nauka.tass.ru/nauka/6817604
https://tass.ru/sci/6822229
https://elementy.ru/nauchno-populyarnaya_biblioteka/433353/P...
14. Исследование на скорость и точность принятия решений
https://royalsocietypublishing.org/doi/full/10.1098/rspb.201...
15. Исследование о различении цветов
https://www.sciencedirect.com/science/article/abs/pii/S15661...
16. Видео и фото
http://dictybase.org/Multimedia/development/development.html